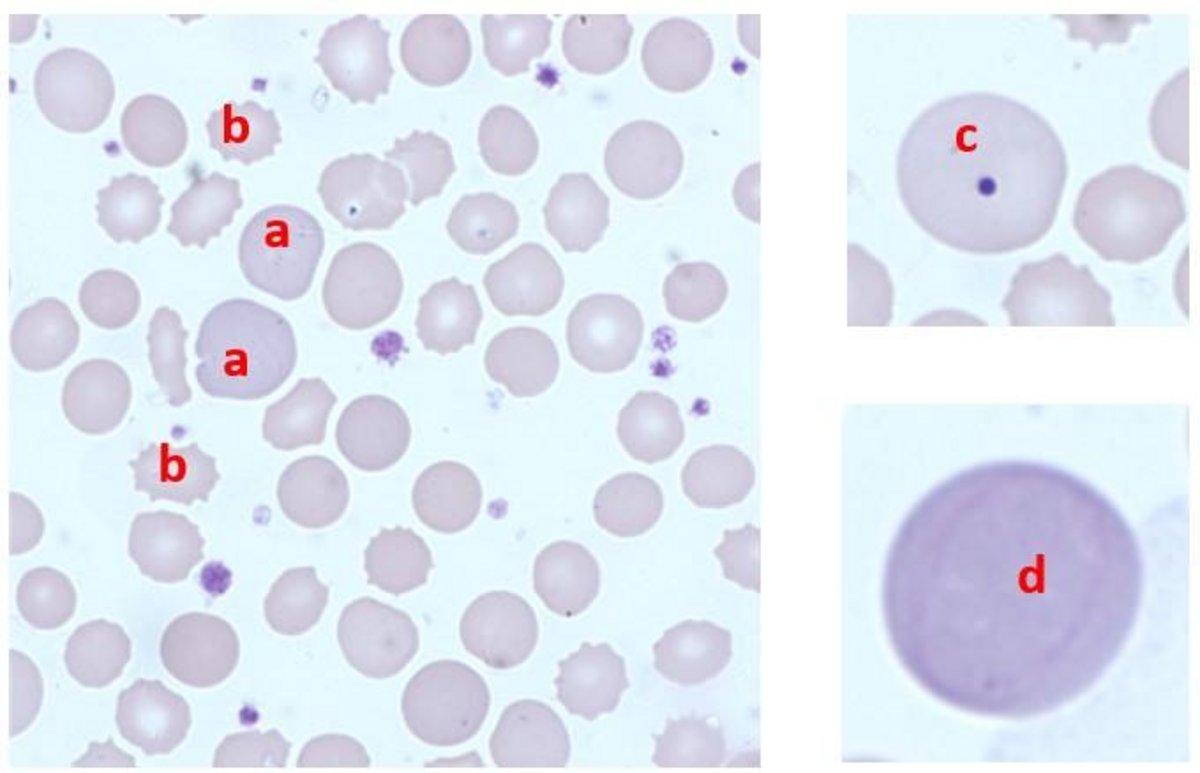

Subscribe to QSP newsletter
Subscribe to our monthly QSP Newsletter to see detailed morphology case studies, disease focuses, morphology tips, slide reviews, and quizzes!
June 2024
Monthly Digital Case Study
Quiz
(PDF for print)
| WBC 37.9* (10^3/mm3) | RDW-SD 78 (fL) |
| RBC 3.01 (10^6/mm3) | RDW-CV 20 (%) |
| HGB 10.1 (g/dL) | Ret# 243 (10^3/mm3) |
| HCT 31.0 (%) | Neutrophils 93.1% |
| MCV 103.1 (fL) | Lymphocytes 1.0% |
| MCH 33.7 (pg) | Monocytes 5.9% |
| MCHC 32.7 (g/dL) | Normoblasts/Erythroblasts 30 |
| PLT 511* (10^3/mm3) |
Male age 69, Intensive Care Unit
Anemia, Neutrophilia,
Anisocytosis +++, Microcytosis ++, Macrocytosis ++
Echinocytes ++, Polychromasia +
Erythroblastosis (acidophilic, polychromatophilic/basophilic)
Punctuated RBC’s, Reticulocytes, Presence of Howell-Jolly Bodies
NOTE: A Cabot ring is visible in the second image of the red blood cell wall
This is from a patient who is currently on Intensive Care Unit (ICU). We don’t know any further details e.g. reason for admission into ICU, what if any surgical procedures had been performed, transfusion history or drug therapy. From the available data, we can see that the patient is anemic with a high MCV and has a high Reticulocyte absolute count indicating a bone marrow response. The raised MCV and Reticulocyte count would lead us to assume that there will be some polychromasia in the blood film. The fact that both the RDW-CV and RDW-SD are raised would indicate an increased degree of Anisocytosis, the shape of the RBC curve may indicate whether there is a dimorphic RBC pattern (as seen sometimes in post transfusion) or whether there is a general difference in size amongst the RBC population. The WBC and Platelet counts are high indicative of infection/post operative/trauma. Depending upon the analyzer used, there may be an increase in the number of NRBC or a flag indicating the possible presence of NRBC.
When focusing down on the blood film the first feature observed is the level of Anisocytosis and the presence of large Polychromatic RBC (a), which contain Punctate Basophilia or Basophilic Stippling. Echinocytes (b) and Nucleated Red Blood Cells appear frequently. If the analyzer WBC is not corrected the WBC for the NRBC then this will need to be done as part of the manual differential. A few Howell Jolly bodies can be seen (c). Platelets are numerous and contain some large platelets.
One very unusual feature seen was the presence of a Cabot ring (d) inside a polychromatic RBC. The Cabot ring can just be seen as a very fine red or violet threadlike ring, Cabot rings may also adopt a figure eight like appearance and are formed from the remnants of the mitotic spindle. The presence of Cabot’s rings is an indication of stressed or disordered erythropoiesis.
The general impression from the blood film is that there is disordered erythropoiesis, the underlying reason can not be elucidated without additional clinical information and further tests.
Do you have any questions or requests? Use this form to contact our specialists.